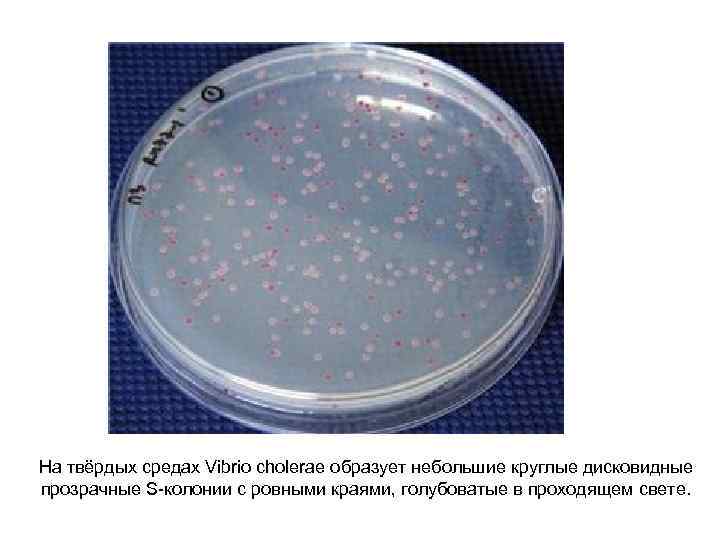
На твёрдых средах Vibrio cholerae образует небольшие круглые дисковидные прозрачные S-колонии с ровными краями,
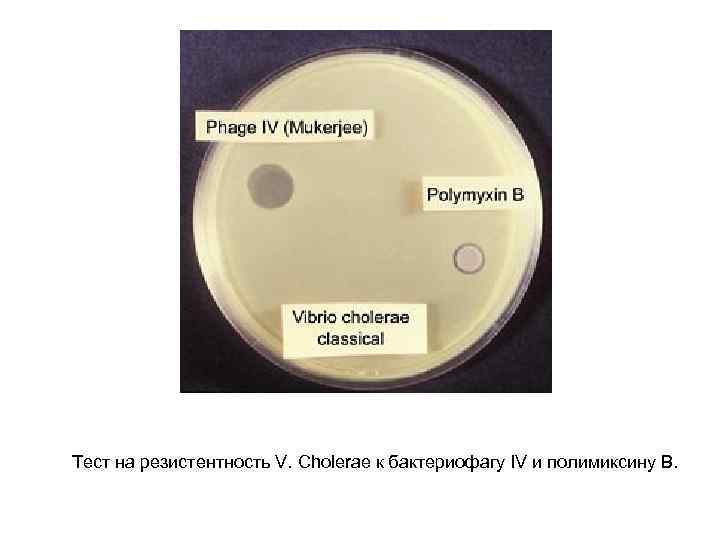
Тест на резистентность V. Cholerae к бактериофагу IV и полимиксину В.

Тема 7 Холера.ppt
- Количество слайдов: 24

Холера • • острая инфекционная болезнь; характеристики: острое начало, гастроэнтеритические проявления, резкое нарушение водно-солевого и белкового обменов, • обезвоживание и тяжелый токсикоз, • тенденция к эпидемическому и пандемическому распространению, • высокая летальность среди нелеченных больных

• Семейство Vibrionaceae • Род Vibrio • Вид Vibrio cholerae • Источник инфекции: человек — больной холерой и здоровый (транзиторный) вибриононоситель. Несмотря на то, что выделение возбудителя в окружающую среду происходит в течение короткого времени, большое количество скрытых форм поддерживает циркуляцию возбудителя. Соотношение носители/больные может достигать от 4: 1 до 10: 1. • Основной механизм передачи – фекально-оральный, реже - контактный. Факторы передачи – вода, пищевые продукты, объекты окружающей среды. Заражение происходит главным образом при питье необеззараженной воды, заглатывании воды при купании в загрязнённых водоёмах и пр.

Биохимические свойства. Сбраживают с образованием кислоты (без газа) глюкозу, сахарозу, мальтозу, маннит, лактозу (сравнительно медленно), левулёзу, гликоген и крахмал. Диагностическое значение имеет ферментация маннозы, сахарозы и арабинозы (триада Хёйберга); холерные вибрионы разлагают только маннозу и сахарозу и принадлежат к 1 группе Хёйберга (по отношению к этим трём углеводам все вибрионы разделяют на 6 групп). Разжижают желатину с образованием «воронки» с пузырьком воздуха вверху, гидролизуют казеин. Обладают плазмокоагулирующим действием (свёртывают плазму кролика) и фибринолитическим (разжижают свёрнутую сыворотку по Лёффлеру). Свёртывают молоко и разлагают другие белки и их дериваты до аммиака и индола. H 2 S не образуют. Восстанавливают нитраты.

Патогенез холеры • Симптомы заболевания вызываются не самим холерным вибрионом, а продуцируемым им холерным токсином. • Входные ворота инфекции - пищеварительный тракт. Вибрионы колонизируют поверхность эпителия тонкого отдела кишечника, не проникая, однако, внутрь его и выделяют экзотоксин (холероген) - термолабильный белок. Экзотоксин способствует выходу в просвет кишечника огромного количества изотонической жидкости с низким содержанием белка и высокой концентрацией ионов натрия, калия, хлоридов, гидрокарбонатов. Развивается диарея, рвота и обезвоживание. Потеря жидкости, гидрокарбонатов и калия ведёт к развитию метаболического ацидоза, гипокалиемии. • Кроме экзотоксина, холерный вибрион имеет эндотоксин термостабильный ЛПС, сходный по структуре и активности с эндотоксинами прочих грамотрицательных бактерий. Эндотоксин проявляет иммуногенные свойства, индуцируя синтез вибриоцидных AT.

• Лабораторная диагностика. • Цель исследований: выявление больных и бактерионосителей; установление окончательного диагноза при исследовании погибших; контроль за эффективностью лечения больных и санации носителей; контроль над объектами внешней среды и эффективностью дезинфекционных мероприятий. • Материалы для исследований - испражнения, рвотные массы, жёлчь, секционный материал (фрагменты тонкой кишки и жёлчного пузыря), постельное и нательное бельё, вода, ил, сточные воды, гидробионты, смывы с объектов окружающей среды, пищевые продукты, мухи и др.

• Наилучшие результаты даёт исследование проб, взятых до начала антибактериальной терапии. • Материал отбирают в стерильную посуду без следа дезсредств. • Испражнения в количестве 10 -20 мл отбирают резиновыми катетерами, или используют ректальные тампоны. • При исследовании желчи отбирают порции В и С (доставляют нативный материал). • Все образцы помещают в герметически закрываемую транспортную тару. Материал следует доставлять в лабораторию не позже 2 ч после забора. При невозможности образцы помещают в транспортные среды (наиболее удобна 1 % пептонная вода с р. Н 8, 2 -8, 6).

• Водопроводную воду (1 л) отбирают в стерильную посуду (по 500 мл) после обжигания кранов и предварительного слива в течение 10 мин. • Сточные воды (1 л) также отбирают в 2 ёмкости. • Гидробионтов (рыб и лягушек, по 10 -15 экземпляров) помещают в герметичные стеклянные банки. • Смывы с объектов отбирают с площади 25 см 2 ватными тампонами, смоченными 1% пептонной водой (в которой их транспортируют в лабораторию). • Для посева используют жидкие среды обогащения, щелочной МПА, элективные и дифференциальнодиагностические среды. • На всех этапах исследования посевы выращивают на пептонной воде 6 -8 ч, пептонной воде с теллуритом калия 12 -18 ч, на щелочном агаре не менее 14 -16 ч, на элективных плотных средах 18 -24 ч. • Для ускоренной диагностики болезни применяют РИФ и РНГА.

• Исследование больных, бактерионосителей и трупного материала проводят в четыре этапа. • I этап. Материал засевают на накопительную среду, на щелочной агар или одну из элективных сред (например, TCBS-arap). • II этап (через 6 -8 ч после начала исследования). Изучают рост на первой среде накопления и производят высев на щелочной агар и вторую среду накопления. Если на первом этапе при исследовании нативного материала ускоренными методами получают положительные результаты, пересев на вторую среду накопления не производят. При отрицательных результатах ускоренные методы повторяют после 6 -часовой инкубации в первой среде накопления.

• III этап (через 12 -14 ч после начала исследования). Изучают рост на второй среде накопления; производят высев со второй среды накопления также на щелочной агар. С чашек отбирают для дальнейших исследований не менее 5 подозрительных колоний и высевают на лактозно-сахарную среду или среду Клиглера. • IV этап (через 18 -24 ч после начала исследования). Проводят отбор подозрительных колоний в посевах на плотные среды нативного материала, а также в посевах со 2 -й накопительной среды.

Морфология Vibrio cholerae изогнутые подвижные грамотрицательные Прямые или палочки, Культуральные свойства. Факультативный анаэроб с более выраженными аэробными свойствами; быстро погибает в анаэробных условиях. Не образует спор. Хорошо растёт на простых питательных средах при высоком р. Н среды (7, 6 -8, 0). На жидких средах вызывает помутнение и образование нежной голубоватой плёнки на поверхности
На твёрдых средах Vibrio cholerae образует небольшие круглые дисковидные прозрачные S-колонии с ровными краями, голубоватые в проходящем свете.

На агаре с тиосульфатом, цитратом, солями жёлчных кислот и сахарозой (TCBS-агар) Vibrio cholerae образует жёлтые колонии.

• Подозрительные колонии исследуют в РА на стекле ( «слайд-агглютинация» ) с О 1 -антисывороткой, а также с сыворотками Инаба и Огава в разведении 1: 50 -100. Если серотипирование вибрионов обычными антисыворотками даёт отрицательный результат, то их проверяют с холерными сыворотками R 0 и 0139 в реакции слайд-агглютинации. • Из культур готовят мазки для окраски по Граму и проб с люминесцирующими сыворотками. Затем проводят биохимическую идентификацию выросших микроорганизмов.

• Антигенная структура. У холерных вибрионов выделяют термостабильные Ои термолабильные Н-Аг. • По структуре О-Аг выделяют 139 серогрупп; • На основании биохимических и биологических различий холерные вибрионы разделяют на 2 биовара (биотипа): классический (V. cholerae asiaticae) и Эль-Тор (V. cholerae eltor). • Возбудители классической холеры и холеры Эль -Тор относятся к О 1 серогруппе (при исследовании на холеру обязательно проводят типирование О 1 -анти-сывороткой). • О-Аг 01 группы холерных вибрионов неоднороден и включает А, В и С компоненты, разные сочетания которых присущи сероварам Огава (АВ), Инаба (АС) и Хикоджима (ABC)

Классификация вибрионов

• В начале 1993 г. появились сообщения о вспышках холеры в юго-восточной Азии, вызванных вибрионами ранее неизвестной серогруппы, обозначенных как серовар 0139 (Бенгал). • Вибрионы серовара 0139 не агглютинируются видоспецифической О 1 и типоспецифическими Огава-, Инаба- и RO-сыворотками, устойчивы к полимиксину и не проявляют гемолитическую активность. • Все Vibrio cholerae лизируются бактериофагом группы IV (по Мукерджи, 1963), а вибрионы биовара Эль-Тор - фагами группы V.
Тест на резистентность V. Cholerae к бактериофагу IV и полимиксину В.

Препараты для специфической профилактики холеры • • • Холероген-анатоксин - очищенный и концентрированный препарат, полученный из центрифугата бульонной культуры холерного вибриона, обезвреженного формалином. Предназначен для создания активного искусственного иммунитета против холеры. Вакцинация и ревакцинация проводятся по эпидемиологическим показаниям однократно за месяц перед эпидемическим сезоном. Холерная вакцина относится к числу убитых корпускулярных вакцин и готовится на основе вирулентных штаммов холерного вибриона классического биотипа или биотипа Эль-Тор серотипов Инаба и Огава, инактивированных нагреванием или формалином. Вакцина холерная бивалентная химическая таблетированная представляет собой смесь холерогена-анатоксина и О-антигенов, полученных из бульонных культур холерного вибриона сероваров Инаба и Огава. Вакцина обеспечивает антибактериальный, антитоксический и местный кишечный иммунитет длительностью до 6 месяцев. Ревакцинацию проводят через 6 -7 мес после первичной вакцинации. Холерный бактериофаг. С тех пор, как в 1926 г. Ф. Д. Эрелль получил хорошие результаты при лечении холеры бактериофагом, этот метод терапии приобрел широкое распространение. Однако в последующем результаты фаготерапии оказались менее обнадеживающими и недостаточно постоянными. Существующие разновидности бактериофага не подавляют развитие вибриона Эль-Тор в организме экспериментальных животных и человека. Согласно заключению Комитета экспертов ВОЗ, в настоящее время нет убедительных материалов, свидетельствующих об эффективности фаготерапии холеры.

Семейство Vibrionaceae 1. изогнутые подвижные палочки 2. распространены повсеместно; широко представлены в морской, пресной воде и часто колонизируют организмы водных животных. 3. хемоорганотрофы; метаболизм окислительный и бродильный 4. температурный оптимум для большинства видов 37°С 5. оксидаза-положительны 6. ферментируют глюкозу и другие углеводы с образованием кислоты. 7. нуждаются во внесении в среду 2 -3% раствора Na. Cl.

Род Vibrio • Род образуют прямые или изогнутые палочки; характерна подвижность (один или несколько жгутиков). • Хемоорганотрофы; метаболизм окислительный и бродильный. Оксидаза-положительны • Температурный оптимум вариабелен; от 20 до 30°С. • Восстанавливают нитраты, D-глюкозу ферментируют до кислоты. Сбраживают мальтозу, маннозу и трегалозу. • Наибольшее медицинское значение имеют V. cholerae, V. parahaemolyticus и V. Vulnificus. Типовой вид рода – V. cholerae.

Прочие патогенные виды Vibrio. • Среди них доминируют поражения, вызванные V. parahaemolyticus и V. vulnificus. • Vibrio parahaemolyticus - галофильный вибрион; возбудитель большинства случаев острых диарей в Японии; вызванные им поражения также регистрируют в странах Юго-Восточной Азии, Африки и Латинской Америки (до 20% диарей), в том числе у туристов. Основные факторы передачи - блюда из морских продуктов, длительно хранимые в тёплом месте и приготовленные с нарушениями технологического процесса. В более редких случаях наблюдают поражения, вызванные употреблением сырых моллюсков и рыбы, а также пищи, обрызганной морской водой. Возбудитель вырабатывает энтеротоксин, вызывающий энтерит.

• Диагностику проводят выделением возбудителя на средах, применяемых для выделения Vibrio cholerae (чаще для исключения холеры) с определением роста на TCBS-arape (образует оливково-зелёные колонии, т. к. не ферментирует сахарозу) и способности утилизировать орнитин. • Vibrio vulnificus входит в состав микробных ценозов эстуариев рек умеренных и тёплых регионов Тихоокеанского и Атлантического побережий и концентрируется в «природных фильтрах» - двухстворчатых моллюсках (устрицах, мидиях, гребешках и т. д. ). Возбудитель обладает уникальной способностью вызывать 2 типа различных поражений септицемии и гнойные раневые процессы.

• Септицемии развиваются после употребления моллюсков и проявляются буллёзными поражениями кожи. Поражения с большей частотой регистрируют у лиц с нарушениями иммунитета, заболеваниями печени, почек и сахарным диабетом. 50% случаев заканчивается летально. • Раневые инфекции обусловлены контактом ран с контаминированной морской водой; они могут быть умеренными либо прогрессировать до тяжёлых целлюлитов и миозитов, имитирующих газовую гангрену. Тяжесть поражений, вызываемых V. vulnificus, зависит от степени патогенности возбудителя и состояния организма. Факторы патогенности - капсула, защищающая бактерии от действия фагоцитов, и комплекс ферментов, включающий цитотоксин-гемолизин, эластазу, коллагеназу и фосфолипазы.

• Поражения наиболее тяжело протекают у лиц с гемохроматозом и циррозом печени (что обусловлено дефектами активности фагоцитов и проникновением бактерий в кровоток). • Диагностику проводят выделением возбудителя на средах, применяемых для Vibrio cholerae, с определением роста на TCBS-arape (образует жёлтые колонии, т. к. ферментирует сахарозу) и способности ферментировать лактозу (50% изолятов V. metschnikovii ферментируют лактозу). • Поражения, вызываемые V. vulnificus, требуют проведения интенсивной антимикробной терапии. Препараты выбора - гентамицин, тетрациклин и левомицетин.
Тема 7 Холера.ppt